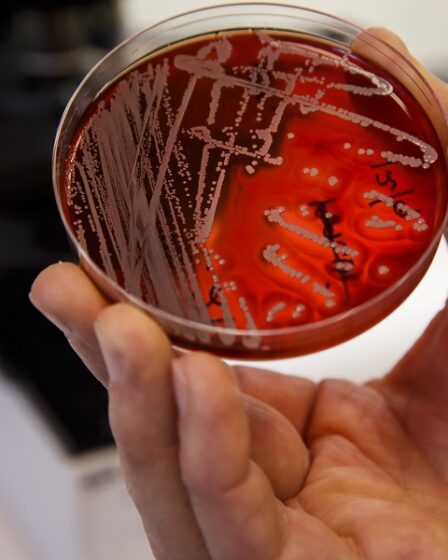
Les Norvégiens risquent de ramener des bactéries résistantes aux antibiotiques chez eux depuis l'étranger 23 Les Norvégiens risquent de ramener des bactéries résistantes aux antibiotiques chez eux depuis l'étranger - 22

Photo : Marit Hommedal / NTB La municipalité d’Askøy a été condamnée à une amende d’un million de NOK en …
Bactéries
Bactéries Listeria détectées dans la nourriture de vol à Norwegian
Norvégien.Photo. Norway.mw Media La bactérie Listeria a été détectée dans les repas servis sur trois vols norvégiens en juillet. Plusieurs …
Environ 70 personnes meurent chaque année de bactéries résistantes en Norvège
Bactéries résistantes.Photo: Cornelius Poppe / NTB scanpix En Europe, 33 000 personnes meurent chaque année des suites d’une résistance aux …
L’Agence norvégienne de sécurité des aliments a imposé une interdiction après des traces de bactéries dans les fraises
L’Autorité norvégienne de sécurité des aliments a constaté des conditions inacceptables pour les cueilleurs de fraises à Vestfold. Plusieurs fermes …
Évitez les bactéries dans les aliments de Noël
Un bon déjeuner ou dîner de Noël durera longtemps, mais tant que les plats sont chauds, ils développeront des bactéries. …
Des bactéries Legionella et du sperme humain trouvés dans certains des plus grands spas de Norvège
Deux des plus grands spas de Norvège ont dû fermer leur bain à remous le lendemain du jour où l’émission …
De plus en plus de bactéries résistantes rentrent en Norvège
Bactéries hospitalières résistantes.Photo: pixabay.com Plus qu’avant, sont infectés par la bactérie multirésistante SARM lorsqu’ils reviennent en Norvège après un séjour …
Les Norvégiens risquent de ramener des bactéries résistantes aux antibiotiques chez eux depuis l’étranger
Selon une nouvelle étude, les Norvégiens qui ont été hospitalisés à l’étranger risquent de ramener chez eux des souches de …
Veut manipuler les bactéries pour ne pas nous rendre malades
Veut manipuler les bactéries pour ne pas nous rendre malades Communiqué de presse (Université d’Oslo / NTB): Des chercheurs de …
Bactéries SARM résistantes aux antibiotiques trouvées chez des porcs au Rogaland
Les porcs élevés en liberté, une rareté dans le farmong moderne. Photo : pixabay.com Une bactérie SARM résistante aux antibiotiques …